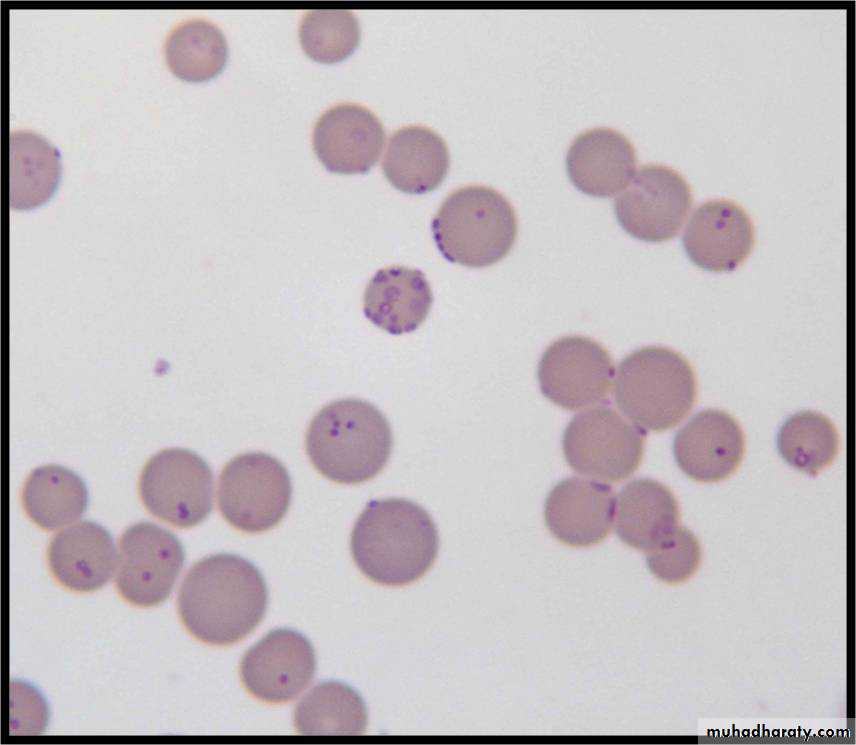

MYCOBACTERIUM TUBERCULOSIS
Mycobacterium tuberculosisHabitat and transmission
Found in infected humans, mainly in the lungs; in the body, it resides primarily in the cells of the reticuloendothelial system; transmission is by coughing (droplet spread).
Characteristics
Acid- and alcohol-fast, slender, beaded bacilli; non-sporing.
As the organisms do not take up the Gram stain because of the long-chain fatty acids (mycolic acid) in the cell wall, a special stain (the Ziehl–Neelsen stain) is required to visualize them.
However, fluorescent microscopy, with auramine stain, is now used commonly for this purpose.
Pathogenicity
This organism is the agent of tuberculosis, a chronic, granulomatous, slowly progressive infection, usually of the lungs; eventually, many other organs and tissues may be affected.A pandemic disease, tuberculosis is especially common in the developing world owing to HIV infection (15–20% of
individuals with HIV disease may have tuberculosis).
The oral cavity is affected secondary to primary disease
The disease granuloma formation and caseation mediated by cellular immunity. No exotoxins or endotoxinAntibiotic sensitivity and control
Long-term therapy (6–9 months) with antituberculous drugs(isoniazid, rifampicin, pyrazinamide, ethambutol).
As drug resistance is growing and a persistent problem, combination
therapy should always be given.Tubercle bacilli resistant to a number of antituberculous drugs (multidrug-resistant tuberculosis (MDR-TB)) is a growing problem.
Hence, regimentation of drug delivery is a cornerstone of managing the disease, which is achieved by a global programme termed directly observed therapy (DOT).
Prevention is
1- by bacille Calmette–Guérin (BCG) vaccination containing live attenuated organisms, in childhood
2- Pasteurization of milk and general improvement of living standards have played a valuable role in prevention
Tubercline skin test
• Mycobacterium bovis
This organism infects cattle. Humans become infected by ingestingM. bovis-contaminated milk.
The organism specifically causes the childhood disease scrofuloderma,
characterized by enlarged, caseous cervical lymph nodes. M. bovis is similar in many respects to M. tuberculosis; in the laboratory, it can be distinguished from the latter by its poor growth on Lowenstein–Jensen medium and ready infection of rabbits.Mycobacterium leprae
Habitat and transmissionHumans are the only known hosts of M. leprae, which resides mainly in the skin and nerves. Prolonged contact is thought to be the mode of transmission.
Characteristics
Aerobic, acid-fast bacilli. no known toxins.
• Habitat and Transmission
Humans are the only known hosts of M. leprae, which resides mainly in the skin and nerves. Prolonged contact is thought to be the mode of transmission.
Characteristics
Aerobic, acid-fast bacilli; no known toxins.
• Pathogenicity
The leprosy bacillus causes a slow,progressive, chronic disease that mainly affects the skin and the nerves; the lesions are predominantly seen in the cooler parts of the body.Two forms of leprosy are recognized
Lepromatous leprosy
The cell-mediated immune response is depressed or absent;M. leprae bacilli are usually seen in large numbers in the lesions and in blood; commonlyinvolves mucosae, especially the nose.
Tuberculoid leprosy
Associated with an intense cell-mediated immune response to the organisms; principally involves the nerves, damage extremities is caused, with resultant loss of fingers and toes.
Mycoplasmas
Mycoplasmas are indeed wall-less bacteria, without the peptidoglycan cell wall but bound by a plasma membrane consisting of lipids and sterols (including cholesterol).Hence, they are highly pleomorphic. The most important species of the genus Mycoplasma is Mycoplasma pneumoniae, which causes:
• a common pneumonia, atypical pneumonia
• mucocutaneous eruptions, including the oral mucosa
• haemolytic anaemia.
Mycoplasma pneumoniae
Primary atypical pneumonia takes the form of fever, nonproductive cough, severe headache, weakness and tiredness.The acute illness lasts for about 2 weeks, but in a majority, the symptoms last longer.
Mucocutaneous eruptions
M. pneumoniae may cause skin rashes and ulcerations of boththe oral and vaginal mucosa.
These appear as maculopapular, vesicular or erythematous eruptions. The skin lesions, which often affect the extremities have iris appearance (target lesions).
In the oral mucosa, erythematous patches may appear first, quickly becoming bullous and erosive.
Oral mycoplasmas
Mycoplasmas have been isolated from saliva, oral mucosa and dental plaque, but their significance is not clear.The oral species are poorly characterized and include Mycoplasma buccale, Mycoplasma orale and Mycoplasma salivarium.
The latter two species have been isolated from salivary glands and are thought to play a role in salivary gland hypofunction.
Chlamydiae
The chlamydiae are a group of microorganisms related to Gram-negative bacteria.However, unlike bacteria, they are unable to grow on culture media.
They are therefore obligatory intracellular parasites.Their main characteristics include the following:
• larger than most viruses and hence visible by light
microscopy
• both DNA and RNA are present
obligate intracellular parasites with a complex growth cycle
• sensitive to tetracycline, erythromycin, sulphonamides.
There are three species in the genus Chlamydia:
**Chlamydia trachomatis is an agent of many diseases** Chlamydia pneumoniae causes acute respiratory tract infection,
including sore throat, mild pneumonia and fever in humans.
** Chlamydia psittaci primarily causes disease (psittacosis)
in birds such as pet parrots and budgerigars,The human infection, also known as psittacosis, takes the form of a
primary atypical pneumonia.
Chlamydia trachomatis
Causes a spectrum of diseases:• ocular infections – neonatal conjunctivitis
(blenorrhoea), keratoconjunctivitis, blindness
(trachoma).
Trachoma is a major cause of blindness in
the developing world
genital infections – non-specific urethritis, the most common sexually transmitted disease. In the tropics, it causes lymphogranuloma venereum and pneumonia – in neonates.
Rickettsiae
Rickettsiae are pleomorphic organisms, smaller than bacteria but resembling them structurally and metabolically, including cell wall formation.They, like Chlamydia and viruses, are obligate intracellular parasites. The best-known huma rickettsial disease is
typhus, which spreads wildly in conditions of malnutrition and poverty.
Rickettsiae are: • coccobacilli, with a multilayered outer cell wall resembling that of Gram-negative bacteria
• obligate intracellular parasites that replicate by binary fission,members of the genus are transmitted to humans via bites of infected arthropods.
• sensitive to tetracycline and chloramphenicol.
There are two genera within the Rickettsieae: Rickettsia andCoxiella.
Rickettsial diseases include:
• typhus, an acute febrile illness, now rare, with amaculopapular rash transmitted by the rat flea; the fatality rate is frequently high as a result of
haemorrhagic complications
• spotted fevers – Rocky Mountain spotted fever and other tick-borne fevers.